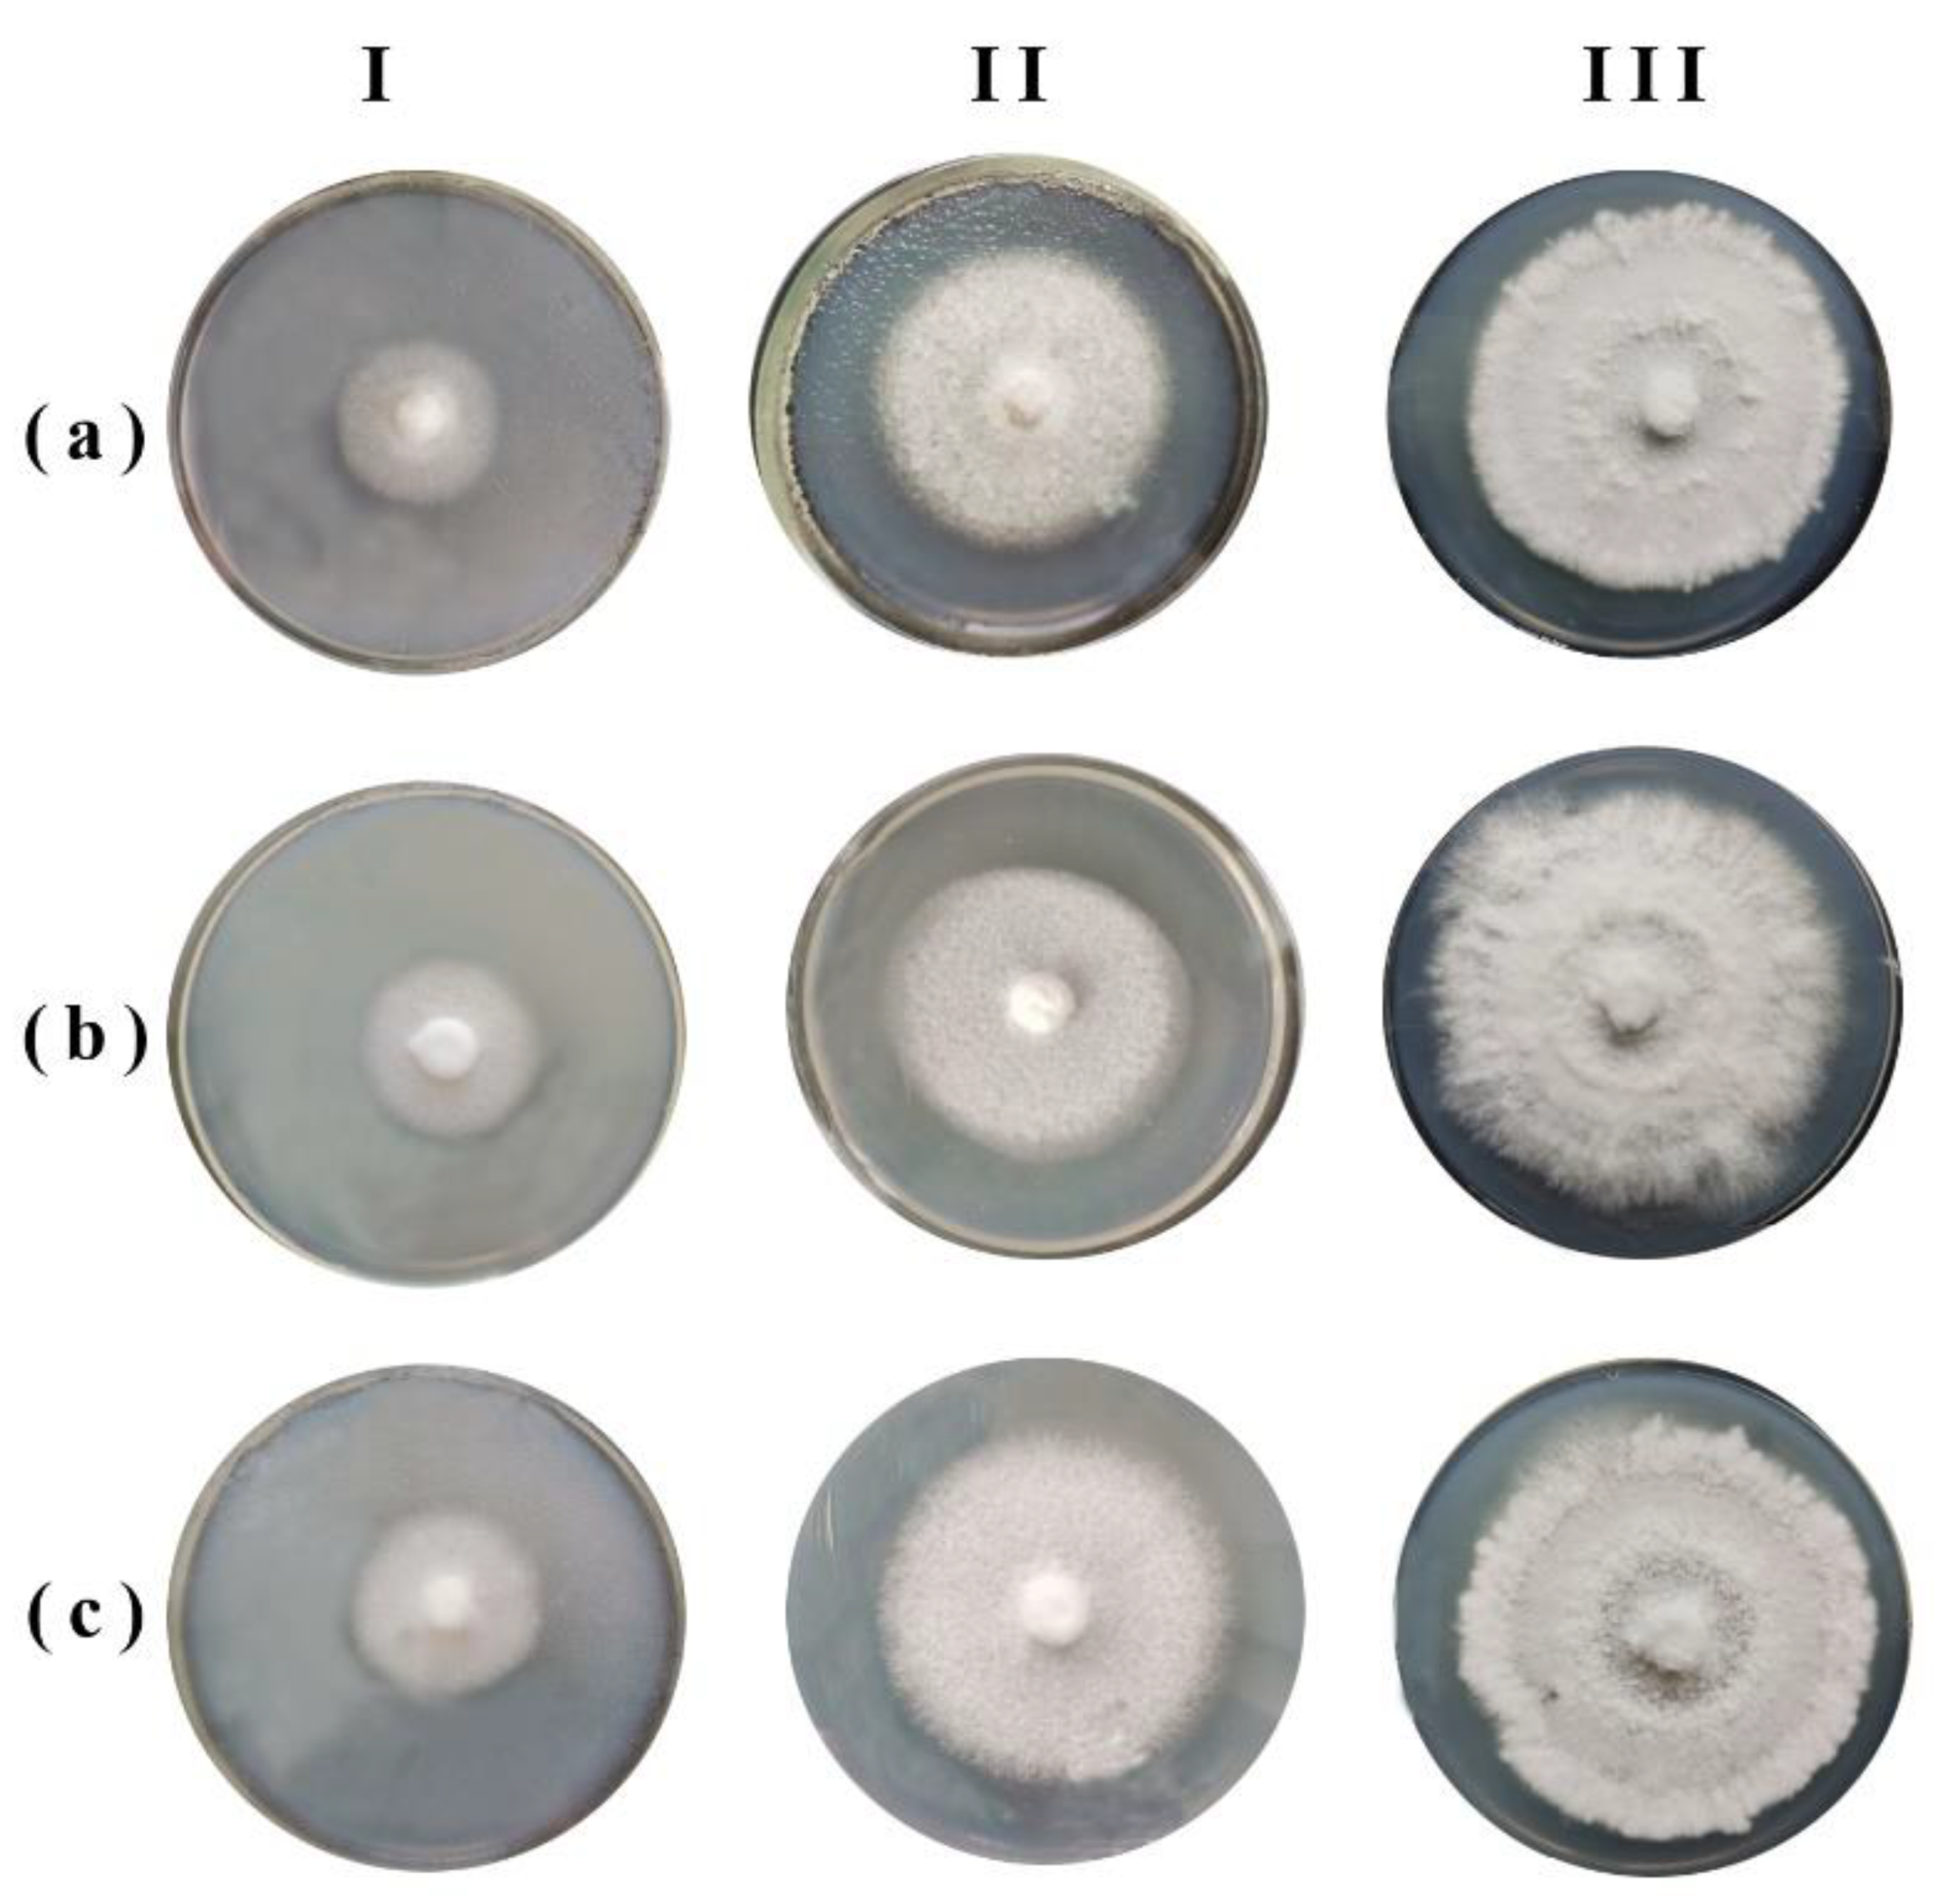
Jof 08 01296 g005 Jof 08 01296 g005

Eco-Physiological Adaptations of the Xylotrophic Basidiomycetes Fungi to CO2 and O2 Mode in the Woody Habitat
Abstract
1. Introduction
2. Materials and Methods
2.1. Objects of Study
2.2. Assessment of the Intensity of Gas Exchange
2.3. Preparation of Gaseous Media with Different Contents of O2 and CO2
2.4. Evaluation of Mycelium Growth under Anoxic Conditions
2.5. Statistical Analysis
3. Results
4. Discussion
Author Contributions
Funding
Data Availability Statement
Acknowledgments
Conflicts of Interest
References
- Gilbertson, R.L. Wood-rotting fungi of North America. Mycologia 1980, 72, 1–49. [Google Scholar] [CrossRef]
- Stepanova, N.T.; Mukhin, V.A. Fundamentals of Wood-Decaying Fungi Ecology; Nauka: Moscow, Russia, 1979; 100p. (In Russian) [Google Scholar]
- Parmasto, E. On origin of the Hymenomycetes (What are corticioid fungi?). Windahlia 1986, 16, 3–19. [Google Scholar]
- Floudas, D.; Binder, M.; Riley, R.; Barry, K.; Blanchette, R.A.; Henrissat, B.; Martinez, A.T.; Otillar, R.; Spatafora, J.W.; Yadav, J.S.; et al. The paleozoic origin of enzymatic lignin decomposition reconstructed from 31 fungal genomes. Science 2012, 336, 1715–1719. [Google Scholar] [CrossRef] [PubMed]
- Henningsson, B. Physiology a decay activity of the birch conk fungus Polyporus betulinus (Bull.) Fr.; Studia Forestalia Suecica; Skogshögskolan: Stockholm, Sweden, 1965; Volume 34, 77p. [Google Scholar]
- Harmon, M.E.; Franklin, J.F.; Swanson, F.J.; Sollins, P.; Gregory, S.V.; Lattin, J.D.; Anderson, N.H.; Cline, S.P.; Aumen, N.G.; Sedell, J.R.; et al. Ecology of Coarse Woody Debris in Temperate Ecosystems. Adv. Ecol. Res. 1986, 15, 133–302. [Google Scholar]
- Dix, N.J.; Webster, J. Fungal Ecology; Chapman and Hall: London, UK, 1995; 549p. [Google Scholar]
- Watkinson, S.; Bebber, D.; Darrah, P.; Fricker, M.; Tlalka, M.; Boddy, L. The role of wood decay fungi in the carbon and nitrogen dynamics of the forest floor. In Fungi in Biogeochemical Cycles; Gadd, G., Ed.; Cambridge University Press: Cambridge, UK, 2006; pp. 151–181. [Google Scholar]
- Isaev, A.S.; Korovin, G.N. Lesa Rossii i Kiotskii protocol (Russian forest and Kyoto protocol). In Vozmozhnosti Predotvrashcheniya Izmeneniya Klimata i Ego Negativnykh Posledstvii: Problema Kiotskogo Protokola: Materialy Soveta-Seminara pri Prezidente RAN (The Possibility of Preventing Climate Change and Its Negative Effects: The Problem of Kyoto Protocol: Seminar Materials at the President Russian Academy of Sciences); Izrael, Y.A., Ed.; Nauka: Moscow, Russia, 2006; pp. 287–305. (In Russian) [Google Scholar]
- Kudeyarov, V.N.; Zavarzin, G.A.; Blagodatskii, S.A.; Borisov, A.V.; Voronin, P.Y.; Demkin, V.A.; Demkina, T.S.; Evdokimov, I.V.; Zamolodchikov, D.G.; Karelin, D.V.; et al. Puly i Potoki Ugleroda v Nazemnykh Ekosistemakh Rossii (Pools and Fluxes of Carbon in Terrestrial Ecosystems Russia); Zavarzin, G.A., Ed.; Nauka: Moscow, Russia, 2007; 315p. (In Russian) [Google Scholar]
- Mukhin, V.A.; Diyarova, D.K.; Gitarskiy, M.L.; Zamolodchikov, D.G. Carbon and Oxygen Gas Exchange in Woody Debris: The Process and Climate-Related Drivers. Forests 2021, 12, 1156. [Google Scholar] [CrossRef]
- Jensen, K.F. Oxygen and carbon dioxide concentrations in sound and decaying red oak trees. For. Sci. 1969, 15, 246–251. [Google Scholar] [CrossRef]
- Soloviev, V.A. Respiratory Gas Exchange of Wood; LGU: Leningrad, Russia, 1987; 300p. (In Russian) [Google Scholar]
- Hintikka, V.; Korhonen, K. Effects of carbon dioxide on the growth of lignicolous and soil-inhabiting Hymenomycetes. Commun. Inst. For. Fenn. 1970, 69, 5–29. [Google Scholar]
- Scheffer, T.C. O2 requirements for growth and survival of wood-decaying and sapwood-staining fungi. Can. J. Bot. 1986, 64, 1957–1963. [Google Scholar] [CrossRef]
- Tabak, H.H.; Cooke, W.B. The effects of gaseous environments on the growth and metabolism of fungi. Bot. Rev. 1968, 34, 126–252. [Google Scholar] [CrossRef]
- Zadradžil, F. Influence of CO2 concentration on the mycelium growth of three Pleurotus species. Eur. J. Appl. Microbiol. 1975, 1, 327–335. [Google Scholar] [CrossRef]
- Highley, T.L.; Bar-Lev, S.S.; Kirk, T.K.; Larsen, M.J. Influence of O2 and CO2 wood decay by heartrot and saprot fungi. Phytopathology 1983, 73, 630–633. [Google Scholar] [CrossRef]
- Tavzes, C.; Pohleven, F.; Koestler, R.J. Effect of anoxic conditions on wood-decay fungi treated with argon or nitrogen. Int. Biodeterior. Biodegrad. 2001, 47, 225–231. [Google Scholar] [CrossRef]
- Seo, G.S.; Suzuki, A. Effect of concentrated carbon dioxide exposure on the mycelial growth and fruit body initiation of Ganoderma lucidum. J. Mushroom Sci. Prod. 2004, 2, 45–48. [Google Scholar]
- Ryvarden, L.; Gilbertson, R.L. European Polypores. Pt. 1 (Abortiporus-Lindtneria); Fungiflora: Oslo, Norway, 1993; 387p. [Google Scholar]
- Kirk, P.M. Index Fungorum. Available online: http://www.indexfungorum.org/names/names.asp (accessed on 10 November 2022).
- Dudka, I.A.; Vasser, S.P.; Ellanskaya, I.A.; Koval, E.Z. Methods of Experimental Mycology; Naukova Dumka: Kiev, Russia, 1982; 552p. (In Russian) [Google Scholar]
- Unden, G. Aerobic respiration and regulation of aerobic/anaerobic metabolism. In Biology of the Prokaryotes; Lengeler, J.W., Drews, G., Schlegel, H.G., Eds.; Thieme: Stuttgart, Germany, 1999; pp. 261–277. [Google Scholar]
- Black, J. Microbiology: Principles and Explorations, 6th ed.; John Wiley & Sons: Hoboken, NJ, USA, 2005; 920p. [Google Scholar]
- Mukhin, V.; Voronin, P. Methane emission during wood fungal decomposition. Dokl. Biol. Sci. 2007, 413, 159–160. [Google Scholar] [CrossRef]
- Keppler, F.; Hamilton, J.T.G.; Braß, M. Methane emissions from terrestrial plants under aerobic conditions. Nature 2006, 439, 187–191. [Google Scholar] [CrossRef] [PubMed]
- Zavarzin, G.A.; Zavarzina, A.G. Xylotrophic and mycophilic bacteria in formation of dystrophic waters. Microbiology 2009, 78, 523–534. [Google Scholar] [CrossRef]
- Mukhortova, L.; Pashenova, N.; Meteleva, M.; Krivobokov, L.; Guggenberger, G. Temperature Sensitivity of CO2 and CH4 Fluxes from Coarse Woody Debris in Northern Boreal Forests. Forests 2021, 12, 624. [Google Scholar] [CrossRef]
- Huang, X.; Liu, X.; Xue, Y.; Pan, B.; Xiao, L.; Wang, S.; Lever, M.; Hinrichs, K.-U.; Inagaki, F.; Liu, C. Methane Production by Facultative Anaerobic Wood-Rot Fungi via a New Halomethane-Dependent Pathway. Microbiol. Spectr. 2022, 10, e0170022. [Google Scholar] [CrossRef] [PubMed]

| Species | Substrates | Basidiocarps |
|---|---|---|
| Daedaleopsis tricolor | 07/0.7/0.9 | 0.8/0.8/0.8 |
| Fomes fomentarius | 1.1/0.7/0.9 | 0.9/0.8/0.9 |
| Fomitopsis betulina | 0.9/0.7/0.9 | 1.0/1.1/0.9 |
| Species | Substrates | Basidiocarps |
|---|---|---|
| Daedaleopsis tricolor | 0.4/0.3/0.3 | 0.1/0.2/0.2 |
| Fomes fomentarius | 1.2/1.2/1.2 | 2.5/2.7/2.5 |
| Fomitopsis betulina | 0.4/0.2/0.4 | 1.4/1.5/1.3 |
| Species | Substrates | Basidiocarps |
|---|---|---|
| Daedaleopsis tricolor | 0.8/07/0.8/2.0 | 0.8/0.8/0.8/3.8 |
| Fomes fomentarius | 0.9/0.7/1.1/2.3 | 0.8/0.8/0.7/3.1 |
| Fomitopsis betulina | 0.8/1.0/0.5/2.2 | 0.8/0.9/0.6/1.2 |
| Species | Substrates | Basidiocarps |
|---|---|---|
| Daedaleopsis tricolor | 0.7/1.3/1.4/0.6 | 0.6/0.4/0.6/0.1 |
| Fomes fomentarius | 3.4/3.0/3.7/0.9 | 2.2/2.8 /1.9/1.3 |
| Fomitopsis betulina | 0.7/0.6/1.2/0.2 | 0.4/ 0.8/0.8/0.3 |
| Subject of Study | Gas Exchange | |
|---|---|---|
| Before Exposure | After Exposure | |
| Substrates | 0.59 ± 0.07 | 0.46 ± 0.06 (p = 0.19) |
| Basidiocarps | 0.88 ± 0.01 | 0.79 ± 0.03 (p = 0.07) |
| Gaseous Medium | 3 Days in Oxygen-Free Medium | 3 Days in Air, after Oxygen-Free Medium |
|---|---|---|
| CO2 | 3.58 ± 0.51 (p = 0.01) * | 4.25 ± 1.32 (p = 0.66) ** |
| N2 | 7.31 ± 0.50 (p = 0.26) * | 5.59 ± 0.55 (p = 0.08) ** |
| Air (control) | 8.57 ± 0.88 | 6.2 ± 0.84 (p = 0.19) ** |
| Species | Before Exposure in Air | Exposure in Oxygen-Free Medium, h | ||
|---|---|---|---|---|
| 16 | 21 | 45 | ||
| Fomes fomentarius | 0.26/0.78 * | 0.21/0.23 | 0.21/0.20 | 0.22/0.22 |
| Hapalopilus rutilans | 1.39/0.29 * | 0.35/0.15 | 0.31/0.08 | 0.22/0.09 |
| Trichaptum biforme | 1.04 ** | 0.26 | 0.27 | 0.23 |
| Fomitopsis betulina | 0.18 ** | 0.11 | 0.17 | 0.13 |
| Species | Subject of Study | Gas Exchange | |
|---|---|---|---|
| Before Exposure in Air | After Exposure in Oxygen-Free Medium | ||
| Daedaleopsis tricolor | substrate | 0.40 ± 0.01 | 0.24 ± 0.01 (p = 0.001) * |
| D. tricolor | basidiocarp | 0.25 ± 0.01 | 0.12 ± 0.01 (p = 0.001) |
| Fomitopsis betulina | substrat | 0.87 ± 0.10 | 0.68 ± 0.04 (p = 0.13) |
| F. betulina | basidiocarp | 0.59 ± 0.05 | 0.39 ± 0.01 (p = 0.01) |
| Fomes fomentarius | substrat | 1.05 ± 0.02 | 0.86 ± 0.01 (p = 0.001) |
| F. fomentarius | basidiocarp | 1.11 ± 0.06 | 1.11 ± 0.05 (p = 0.99) |
Publisher’s Note: MDPI stays neutral with regard to jurisdictional claims in published maps and institutional affiliations. |
© 2022 by the authors. Licensee MDPI, Basel, Switzerland. This article is an open access article distributed under the terms and conditions of the Creative Commons Attribution (CC BY) license (https://creativecommons.org/licenses/by/4.0/).
Share and Cite
Mukhin, V.A.; Diyarova, D.K. Eco-Physiological Adaptations of the Xylotrophic Basidiomycetes Fungi to CO2 and O2 Mode in the Woody Habitat. J. Fungi 2022, 8, 1296. https://doi.org/10.3390/jof8121296
Mukhin VA, Diyarova DK. Eco-Physiological Adaptations of the Xylotrophic Basidiomycetes Fungi to CO2 and O2 Mode in the Woody Habitat. Journal of Fungi. 2022; 8(12):1296. https://doi.org/10.3390/jof8121296
Chicago/Turabian StyleMukhin, Victor A., and Daria K. Diyarova. 2022. "Eco-Physiological Adaptations of the Xylotrophic Basidiomycetes Fungi to CO2 and O2 Mode in the Woody Habitat" Journal of Fungi 8, no. 12: 1296. https://doi.org/10.3390/jof8121296
APA StyleMukhin, V. A., & Diyarova, D. K. (2022). Eco-Physiological Adaptations of the Xylotrophic Basidiomycetes Fungi to CO2 and O2 Mode in the Woody Habitat. Journal of Fungi, 8(12), 1296. https://doi.org/10.3390/jof8121296

